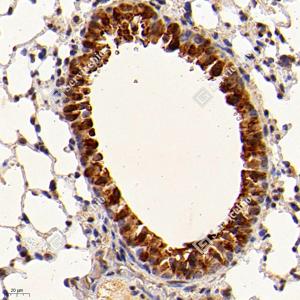
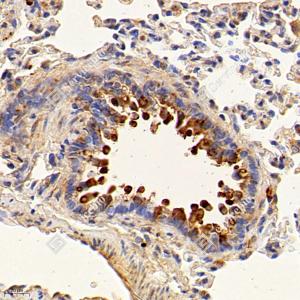
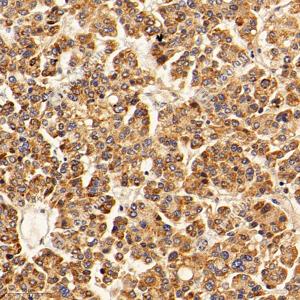
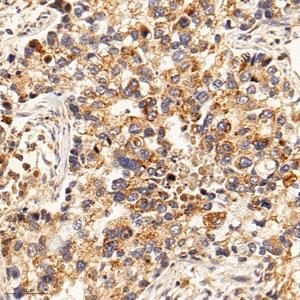
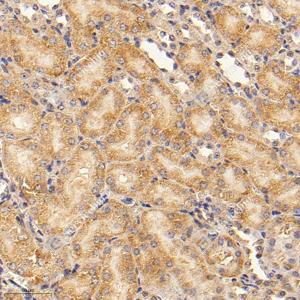
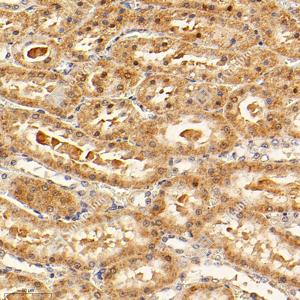

Anti-FKBP6 Rabbit pAb
- 50 μL
产品信息
|
蛋白质全称 |
失活的肽基脯氨酰顺反异构酶FKBP6 |
|
别名 |
36 kDa FK506 binding protein, 36 kDa FKBP, FK506 binding protein 6, FK506 binding protein 6, 36kDa, FKBP 36, FKBP 6, FKBP36, FKBP6, Immunophilin FKBP36, PPIase, PPIase FKBP6, Rotamase |
|
Uniprot ID |
Q91XW8 |
|
免疫原 |
KLH偶联的小鼠FKBP6合成肽 |
|
抗体亚型 |
IgG |
|
纯化方式 |
亲和纯化 |
|
亚细胞定位 |
细胞质, 细胞核 |
应用
| 应用 | 物种 | 稀释 | 阳性样品 |
| IHC/IF 免疫组织化学/免疫荧光 | 人, 小鼠, 大鼠 | 1: 1000-1: 3000 | 肺癌, 肝癌, 肾 |
背景
Co-chaperone required during spermatogenesis to repress transposable elements and prevent their mobilization, which is essential for the germline integrity. Acts via the piRNA metabolic process, which mediates the repression of transposable elements during meiosis by forming complexes composed of piRNAs and Piwi proteins and govern the methylation and subsequent repression of transposons. Acts as a co-chaperone via its interaction with HSP90 and is required for the piRNA amplification process, the secondary piRNA biogenesis. May be required together with HSP90 in removal of 16 nucleotide ping-pong by-products from Piwi complexes, possibly facilitating turnover of Piwi complexes.
图像
|
|
IHC检测FKBP6蛋白(货号 GB114949). 样品: 小鼠肺癌, 4%多聚甲醛 (货号G1101) 固定12-24小时. 抗原修复: Tris-EDTA抗原修复液(pH 9.0) (G1203), 98℃, 20分钟. —抗: 1: 1000稀释, 4℃ 孵育过夜. 二抗: HRP标记山羊抗兔IgG (H+L) (货号GB23303), 1: 200稀释, 室温孵育1小时. |
|
|
IHC检测FKBP6蛋白(货号 GB114949). 样品: 大鼠肺癌, 4%多聚甲醛 (货号G1101) 固定12-24小时. 抗原修复: Tris-EDTA抗原修复液(pH 9.0) (G1203), 98℃, 20分钟. —抗: 1: 1000稀释, 4℃ 孵育过夜. 二抗: HRP标记山羊抗兔IgG (H+L) (货号GB23303), 1: 200稀释, 室温孵育1小时. |
|
|
IHC检测FKBP6蛋白(货号 GB114949). 样品: 人肝癌, 4%多聚甲醛 (货号G1101) 固定12-24小时. 抗原修复: Tris-EDTA抗原修复液(pH 9.0) (G1203), 98℃, 20分钟. —抗: 1: 1000稀释, 4℃ 孵育过夜. 二抗: HRP标记山羊抗兔IgG (H+L) (货号GB23303), 1: 200稀释, 室温孵育1小时. |
|
|
IHC检测FKBP6蛋白(货号 GB114949). 样品: 人肺癌, 4%多聚甲醛 (货号G1101) 固定12-24小时. 抗原修复: Tris-EDTA抗原修复液(pH 9.0) (G1203), 98℃, 20分钟. —抗: 1: 1000稀释, 4℃ 孵育过夜. 二抗: HRP标记山羊抗兔IgG (H+L) (货号GB23303), 1: 200稀释, 室温孵育1小时. |
|
|
IHC检测FKBP6蛋白(货号 GB114949). 样品: 小鼠肾, 4%多聚甲醛 (货号G1101) 固定12-24小时. 抗原修复: Tris-EDTA抗原修复液(pH 9.0) (G1203), 98℃, 20分钟. —抗: 1: 1000稀释, 4℃ 孵育过夜. 二抗: HRP标记山羊抗兔IgG (H+L) (货号GB23303), 1: 200稀释, 室温孵育1小时. |
|
|
IHC检测FKBP6蛋白(货号 GB114949). 样品: 大鼠肾, 4%多聚甲醛 (货号G1101) 固定12-24小时. 抗原修复: Tris-EDTA抗原修复液(pH 9.0) (G1203), 98℃, 20分钟. —抗: 1: 1000稀释, 4℃ 孵育过夜. 二抗: HRP标记山羊抗兔IgG (H+L) (货号GB23303), 1: 200稀释, 室温孵育1小时. |
储存
| 储存条件 | 在-20℃下储存一年, 避免反复冻融. |
| 储存缓冲液 | 含0.15% ProClin300防腐剂, 100 μg/mL牛血清白蛋白和50%甘油的磷酸盐缓冲液. |
注意:
1.本产品仅供研究使用.
2.建议用一抗稀释液(G2025)稀释本产品.
| 货号 | 名称 | 规格 | 价格 | 操作 |
|---|
| 货号 | 名称 | 规格 | 价格 | 操作 |
|---|